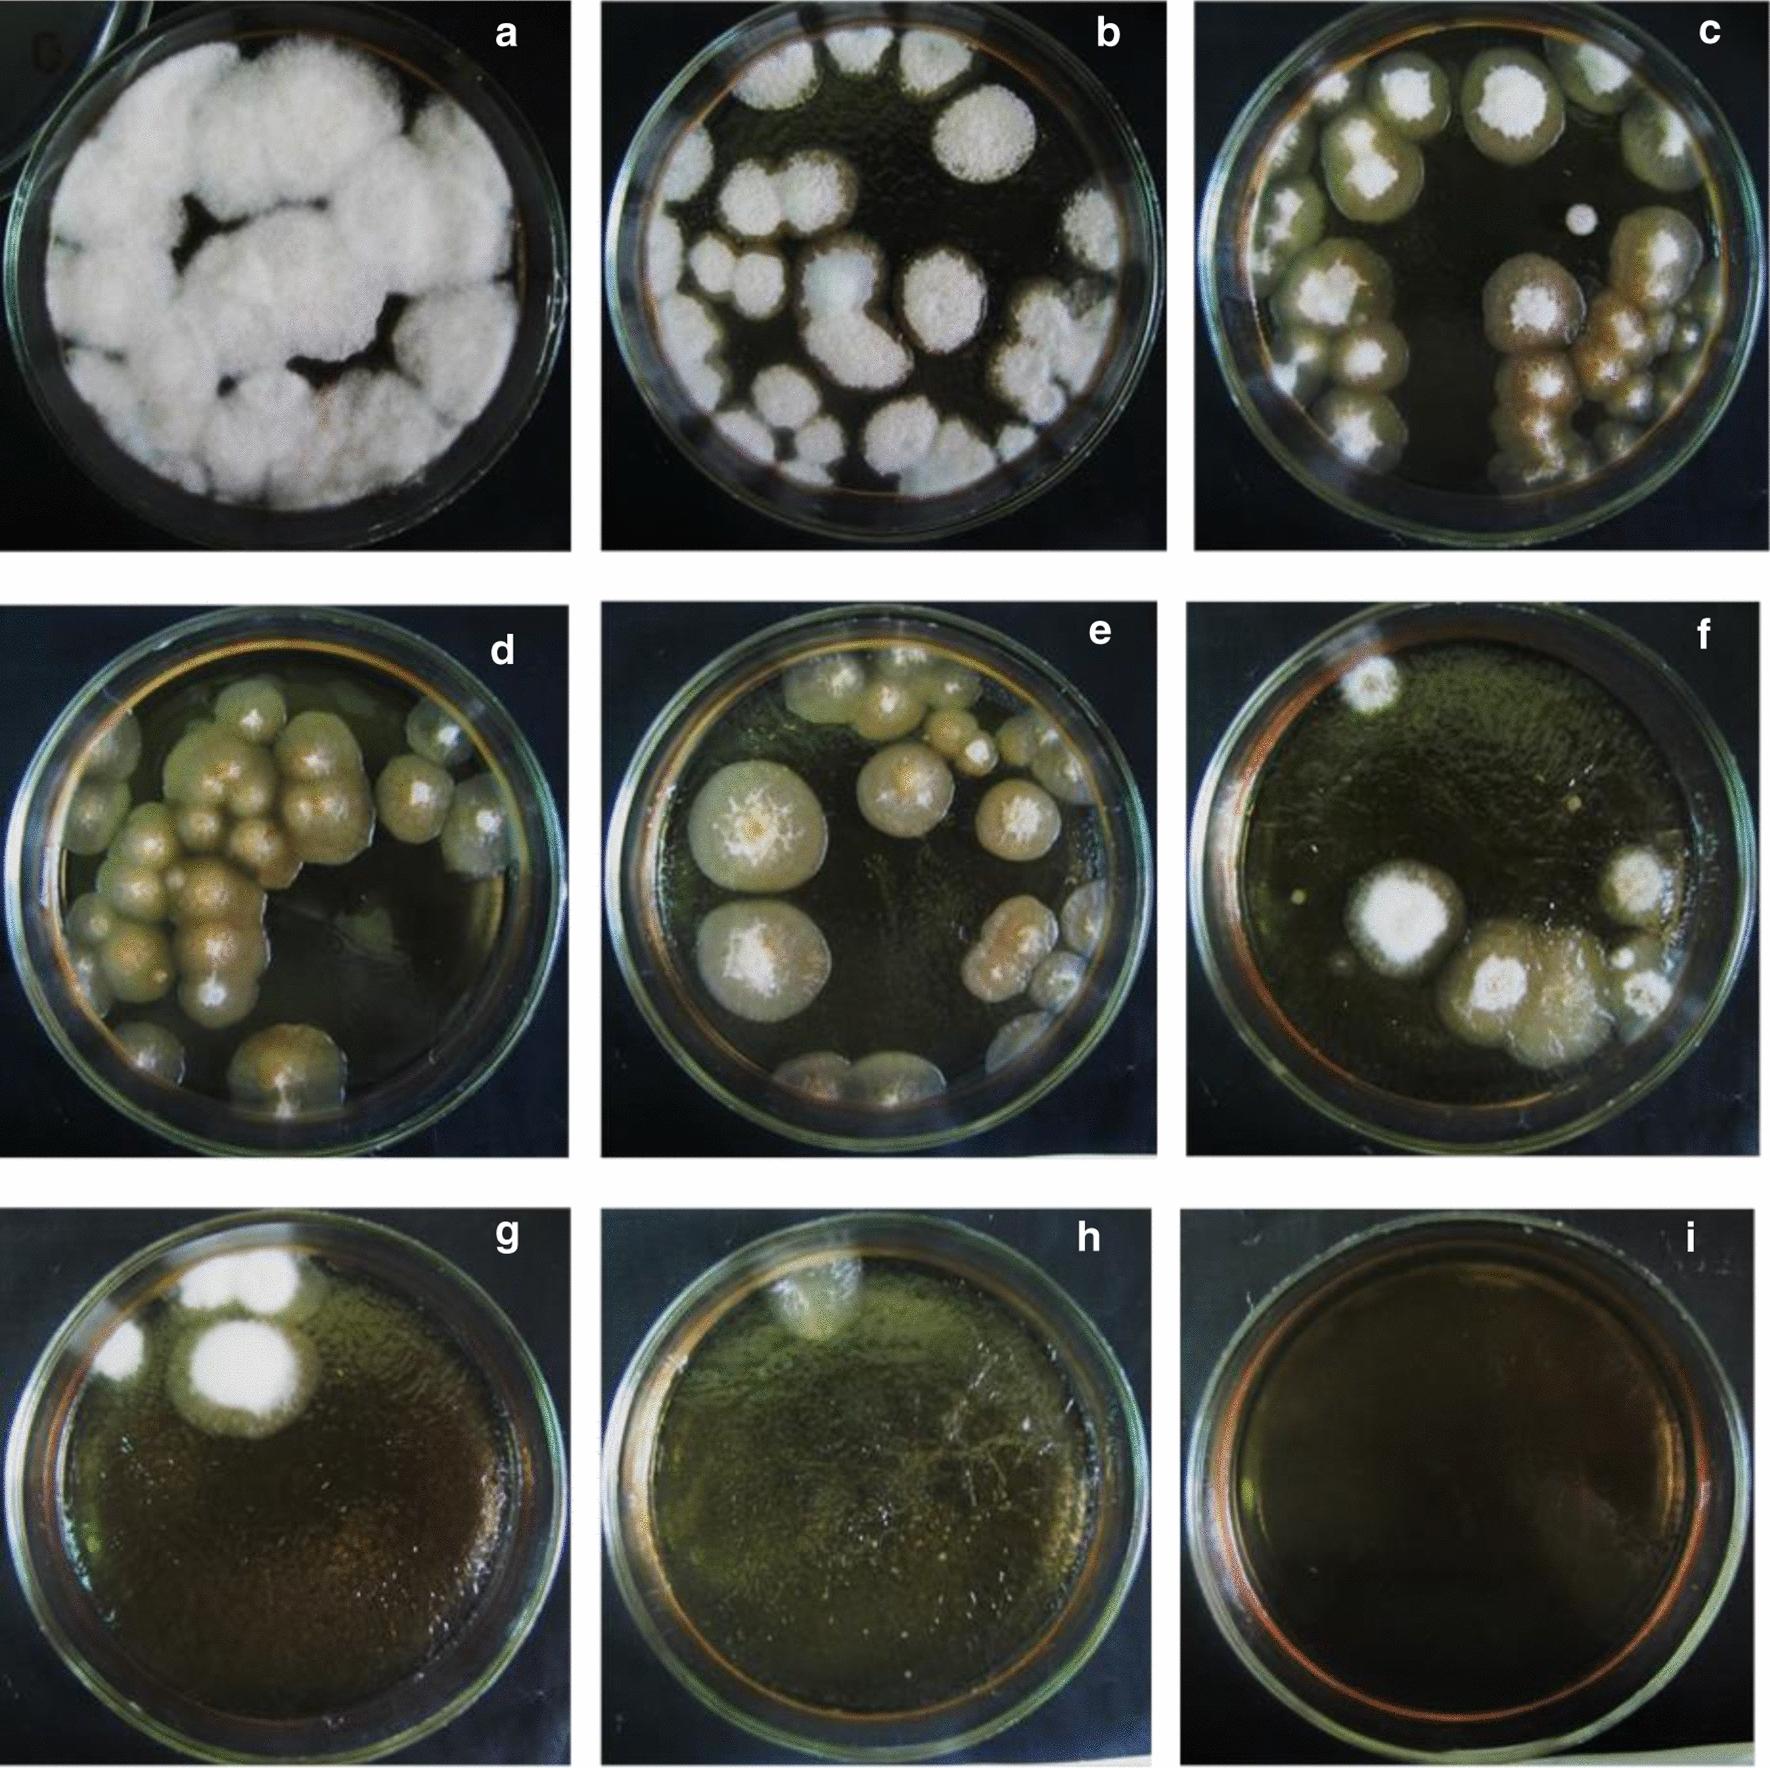

赤霉病菌突变体产生熊去氧胆酸的研究
Ursodeoxycholic acid production by Gibberella zeae mutants.
作者信息
Kollerov Vyacheslav, Donova Marina
机构信息
Federal Research Center Pushchino Center for Biological Research of the Russian Academy of Sciences, G.K. Skryabin Institute of Biochemistry and Physiology of Microorganisms, Russian Academy of Sciences, Prospekt Nauki, 5, 142290, Pushchino, Moscow Region, Russia.
出版信息
AMB Express. 2022 Aug 8;12(1):105. doi: 10.1186/s13568-022-01446-2.
Ursodeoxycholic acid (UDCA) is a highly demanded pharmaceutical steroid widely used in medicine. An ascomycete Gibberella zeae VKM F-2600 is capable of producing UDCA by 7β-hydroxylation of lithocholic acid (LCA). The present study is aimed at the improvement of the fungus productivity. The original procedures for the protoplast obtaining followed by UV mutagenesis and screening of ketoconazole-resistant mutant clones have been applied. The highest yield of G. zeae protoplasts was obtained when using the mycelium in the active growth phase, ammonium chloride as an osmotic stabilizer and treatment of the fungal cells by the lytic enzymes cocktail from Trichoderma hurzanium. The conditions for effective protoplast regeneration and the UV-mutagenesis were found to provide 6-12% survival rate of the protoplasts with superior number of possible mutations. Three of 27 ketoconazole-resistant mutant clones obtained have been selected due to their increased biocatalytic activity towards LCA. The mutant G. zeae M23 produced 26% more UDCA even at relatively high LCA concentration (4 g/L) as compared with parent fungal strain, and the conversion reached 88% (w/w). The yield of UDCA reached in this study prefers those ever reported. The results contribute to the knowledge on ascomycete mutagenesis, and are of importance for biotechnological production of value added cholic acids.
熊去氧胆酸(UDCA)是一种在医学上广泛使用的高需求药用甾体。子囊菌赤霉菌VKM F - 2600能够通过石胆酸(LCA)的7β - 羟基化作用产生UDCA。本研究旨在提高该真菌的生产力。已应用了原生质体获取、随后进行紫外线诱变以及筛选酮康唑抗性突变克隆的原始程序。当使用处于活跃生长阶段的菌丝体、氯化铵作为渗透稳定剂并用来自哈茨木霉的裂解酶混合物处理真菌细胞时,获得了最高产量的赤霉菌原生质体。发现有效的原生质体再生和紫外线诱变条件可使原生质体的存活率达到6 - 12%,且可能的突变数量更多。从获得的27个酮康唑抗性突变克隆中,选择了3个因其对LCA的生物催化活性增加。与亲本真菌菌株相比,突变体赤霉菌M23即使在相对较高的LCA浓度(4 g/L)下也能多产生26%的UDCA,转化率达到88%(w/w)。本研究中获得的UDCA产量优于以往报道的产量。这些结果有助于了解子囊菌的诱变作用,对于增值胆酸的生物技术生产具有重要意义。